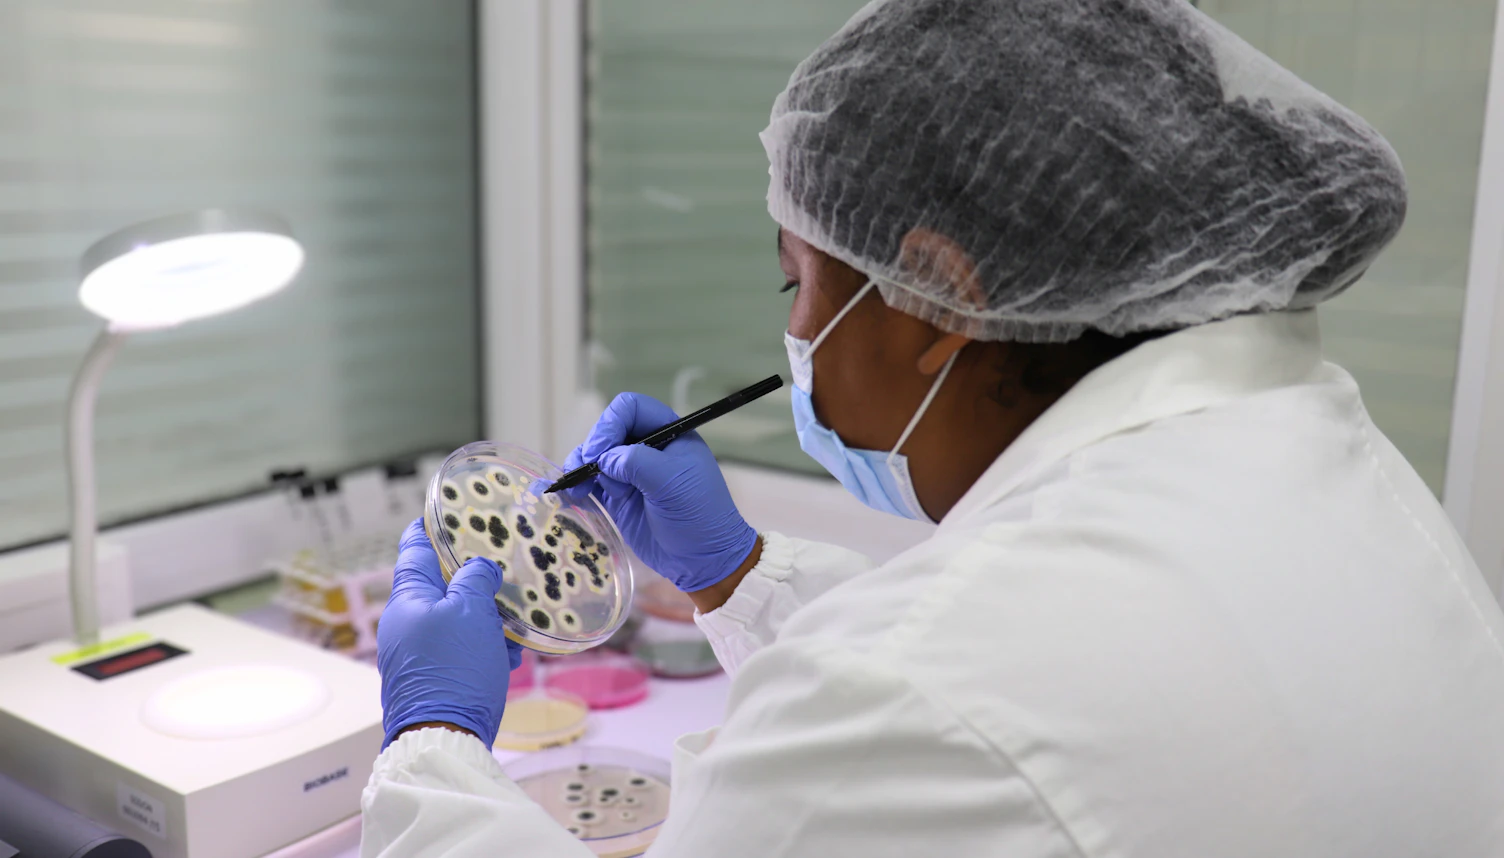

We are pleased to announce that we are strengthening local access to reliable food microbiology and water testing services in Madagascar with the launch of a new laboratory in Antananarivo.
Designed to support businesses, exporters and public institutions, this facility provides high-quality analyses aligned with both local and international requirements. It helps organizations improve quality control, strengthen risk management and ensure regulatory compliance.
The laboratory is progressing towards full operational readiness, including method validation and future ISO/IEC 17025 accreditation, which will further confirm the reliability and technical competence of its testing processes.
Why this matters
Reliable local testing plays a key role in supporting Madagascar’s agrifood and water sectors. It enables businesses to better control quality, meet export requirements and respond more effectively to regulatory expectations.
With agrifood exports highly dependent on compliance, access to trusted local analysis helps reduce delays, costs and the risk of rejected shipments.
For water testing, the laboratory also provides an essential local resource for monitoring potable water, wastewater and seawater, supporting both operational compliance and public health priorities.
What services are available?
The laboratory performs a wide range of microbiological analyses to assess food safety, hygiene and water quality.
Food testing includes:
- Yeasts and molds
- Total microorganism counts
- Coliform and thermotolerant bacteria
- Escherichia coli
- Salmonella spp.
- Listeria monocytogenes
- Coagulase-positive staphylococci
Water testing includes:
- Coliform and fecal bacteria
- Escherichia coli
- Salmonella spp.
- Legionella spp. including pneumophila
- Intestinal enterococci
- Clostridium perfringens
- Pseudomonas aeruginosa
- Total microorganism counts

The laboratory analyzes a broad range of sample types, including bottled water, drinking water, effluents, ice, surface water, raw foods, ready-to-eat products, feeds and feed products.
It also carries out surface swab testing and hand sampling for hygiene monitoring, as well as environmental monitoring programs for pathogen detection, including Listeria and Salmonella.
What are the benefits?
With this new laboratory, we enhance our ability to meet growing demand for dependable microbiological analysis. Key benefits include:
- Faster turnaround through local sample processing
- Closer support from a trusted partner based in Madagascar
- Reliable analyses aligned with recognized local and international standards, including EU, FDA and Codex
- Stronger support for exporters seeking to reduce compliance risks
These services contribute to improved food safety and water quality monitoring, while supporting both private sector development and public health.
Part of our broader offer in Madagascar
Since 2004, we have supported exporters, manufacturers and institutions across Madagascar. Beyond food and water testing, we offer inspection, certification and training services, as well as sector-specific solutions in energy, minerals, agricultural commodities, logistics, construction and textiles.
This broad expertise allows us to support clients with a comprehensive approach to quality, compliance and operational risk, all through one trusted partner.
For further information, please contact:
Daniel Julie
Regional Sales and Business Development Manager
Business Assurance
t: +261 32 14 704 86
About SGS
SGS is the world’s leading Testing, Inspection and Certification company. We operate a network of over 2,500 laboratories and business facilities across 115 countries, supported by a team of over 100,000 dedicated professionals. With more than 145 years of service excellence, we combine the precision and accuracy that define Swiss companies to help organizations achieve the highest standards of quality, compliance and sustainability.
Our brand promise – when you need to be sure – underscores our commitment to trust, integrity and reliability, enabling businesses to thrive with confidence. We proudly deliver our expert services through the SGS name and a portfolio of trusted specialized brands, including Applied Technical Services, Brightsight, Bluesign and Nutrasource.
SGS is publicly traded on the SIX Swiss Exchange under the ticker symbol SGSN (ISIN CH1256740924, Reuters SGSN.S, Bloomberg SGSN SW).



